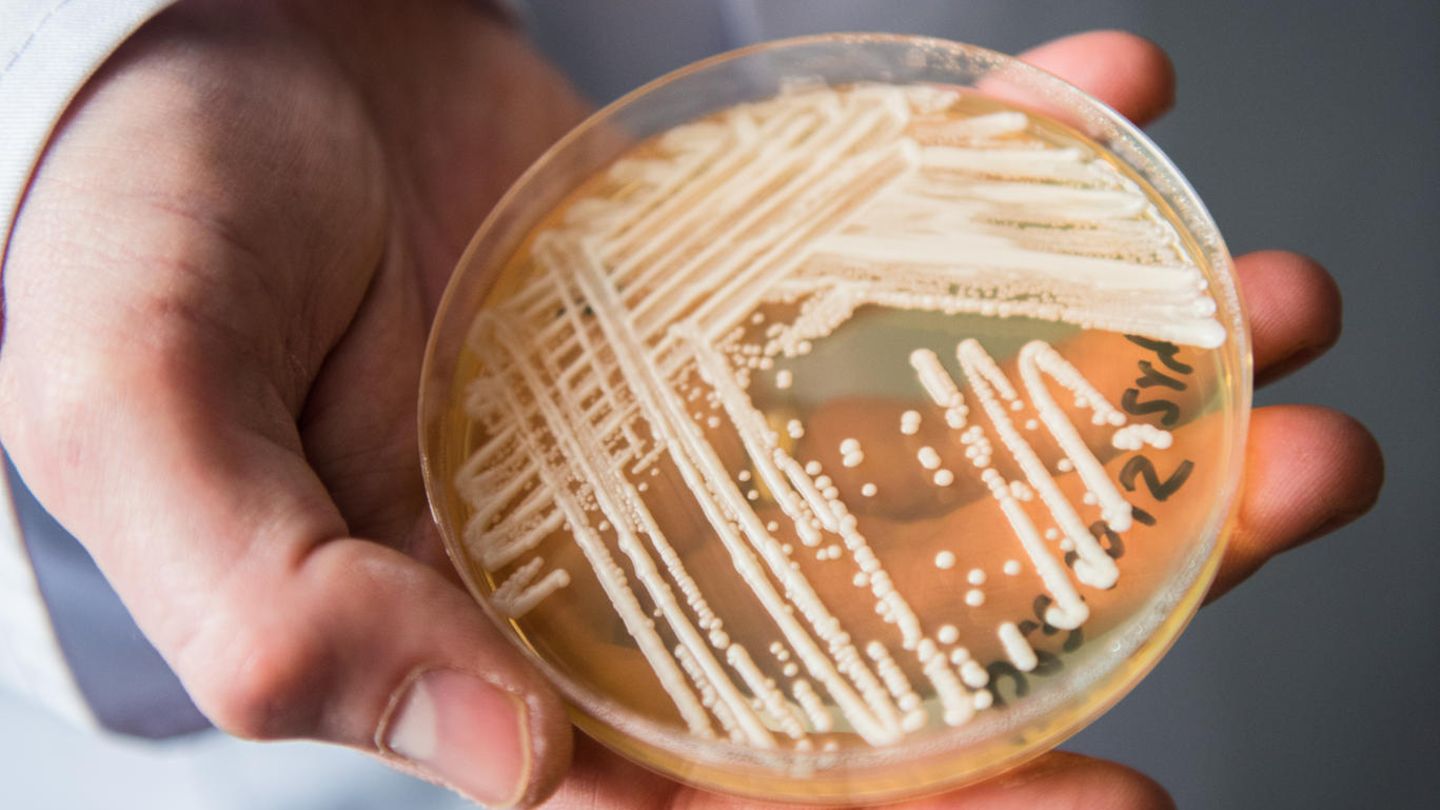

In Deutschland werden immer mehr Fälle bekannt, in denen schwer kranke Patienten mit dem gefährlichen Hefepilz Candida auris infiziert sind. "Wir wissen von insgesamt sieben Patienten, die Candida auris hatten. Davon sind fünf aus dem vergangenen Jahr", sagte Oliver Kurzai vom Nationalen Referenzzentrum für invasive Pilzinfektionen mit Sitz in Jena. Wegen des Hefepilzes gestorben sei hierzulande noch niemand. "Bei den Patienten, von denen wir es wissen, gibt es keine durch die Infektion bedingten Todesfälle", sagte Zentrumsleiter Kurzai vom Lehrstuhl für Medizinische Mikrobiologie und Mykologie der Universität Würzburg.
2015 war der Hefepilz erstmals bei zwei Patienten in Deutschland gefunden worden. "Alle Fälle traten bislang in unterschiedlichen Krankenhäusern auf. Es sind soweit wir wissen Einzelfälle", so Kurzai. Eines hatten die Männer und Frauen jedoch gemeinsam: Sie alle waren schwer krank. "Das sind Patienten, die zum Teil mit schwersten Grunderkrankungen im Krankenhaus sind."
Fallzahlen in Deutschland werden wohl weiter steigen
Der Hefepilz war 2009 in Asien erstmals nachgewiesen worden. Seitdem breitet er sich rasend schnell in der Welt aus. Zuletzt wurden in den USA, Großbritannien und Indien zahlreiche Erkrankungen erfasst.
Kurzai geht davon aus, dass die Fallzahlen auch in Deutschland weiter steigen werden. "Das Risiko sehe ich als relativ erheblich an. Aufgrund der immer weiter zunehmenden globalen Mobilität breiten sich solche Erreger schnell aus. Es ist deshalb nur eine Frage der Zeit, bis wir ihn häufiger in Deutschland sehen."
Anlass zu großer Sorge sieht der Experte nicht. "Es ist eine bedrohliche Krankheit und wir wissen nicht genau, wie wir sie behandeln müssen. Aber es ist nicht Ebola", sagte Kurzai. In Deutschland sei der Pilz, der in allen Fällen mit hoher Wahrscheinlichkeit von den Patienten aus anderen Ländern mitgebracht worden war, noch nicht weiterverbreitet worden.
Resistenter Hefepilz: Gefährlich, "aber nicht Ebola"
Der Hefepilz ist gegen viele Anti-Pilz-Mittel resistent. Dennoch können betroffene Patienten mit vorhandenen Medikamenten behandelt werden. "Man muss ein bisschen gucken, aber es ist nicht so, dass wir mit dem Rücken zur Wand stehen", sagt Kurzai. Für einen gesunden Menschen ist der Pilz keine Bedrohung.
Candida auris kann zu Blutvergiftungen sowie Harnwegs- und Wundinfektionen führen. Spezielle Symptome für den Pilz sind Kurzai zufolge noch nicht erfasst, er kann deshalb nur im Labor identifiziert werden. Der Hefepilz ist noch nicht meldepflichtig.
Kurzai und sein Team hoffen dennoch, dass Kliniken und Labore Verdachtsfälle zur Auswertung an das Referenzzentrum schicken.
Das sei auch für die künftige Behandlung wichtig. "Es besteht das Risiko, dass sich mit Candida auris eine neue Pilzart in unseren Kliniken etabliert, die schwerer zu behandeln ist als die Arten, die wir vorher gesehen haben." Im Moment aber seien die bekannten Fälle noch "absolute Raritäten".